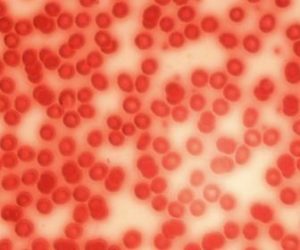

Coronavirus: mio padre di nuovo grave e mia mamma sintomatica che implora un tampone
In questo venerdì santo desideriamo riprendere una storia, che fotografa i tanti volti del dolore, che risponde al nome Coronavirus. Sulle nostre pagine, qualche settimana